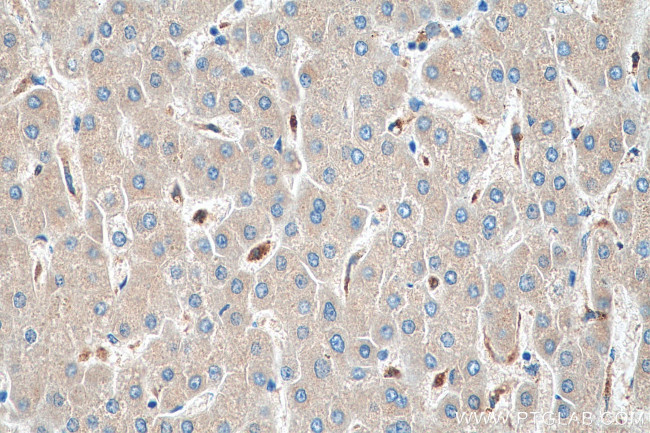
COX4NB Antibody in Immunohistochemistry (Paraffin) (IHC (P))

Search
Proteintech
COX4NB Monoclonal Antibody (2B8D3)
{{$productOrderCtrl.translations['antibody.pdp.commerceCard.promotion.promotions']}}
{{$productOrderCtrl.translations['antibody.pdp.commerceCard.promotion.viewpromo']}}
{{$productOrderCtrl.translations['antibody.pdp.commerceCard.promotion.promocode']}}: {{promo.promoCode}} {{promo.promoTitle}} {{promo.promoDescription}}. {{$productOrderCtrl.translations['antibody.pdp.commerceCard.promotion.learnmore']}}
产品信息
66547-1-IG
种属反应
宿主/亚型
分类
类型
克隆号
抗原
偶联物
形式
浓度
纯化类型
保存液
内含物
保存条件
运输条件
产品详细信息
Immunogen sequence: MPGVKLTTQ AYCKMVLHGA KYPHCAVNGL LVAEKQKPRK EHLPLGGPGA HHTLFVDCIP LFHGTLALAP MLEVALTLID SWCKDHSYVI AGYYQANERV KDASPNQVAE KVASRIAEGF SDTALIMVDN TKFTMDCVAP TIHVYEHHEN RWRCRDPHHD YCEDWPEAQR ISASLLDSRS YETLVDFDNH LDDIRNDWTN PEINKAVLHL C (1-210 aa encoded by BC001472)
靶标信息
EMC8 (ER Membrane Protein Complex Subunit 8) is a Protein Coding gene. An important paralog of this gene is EMC9.[GeneCards]
仅用于科研。不用于诊断过程。未经明确授权不得转售。
生物信息学
蛋白别名: COX4 neighbor; ER membrane protein complex subunit 8; family with sequence similarity 158, member B; Neighbor of COX4; Protein FAM158B; unnamed protein product
基因别名: C16orf2; C16orf4; COX4AL; COX4NB; EMC8; FAM158B; NOC4
UniProt ID: (Human) O43402, (Mouse) O70378, (Rat) Q5FVL2
Entrez Gene ID: (Human) 10328, (Mouse) 18117, (Rat) 361425